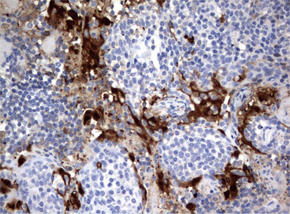

IDO1 を特異的に検出する「UltraMAB® 抗体」です。免疫組織染色(IHC)に最適です
免疫組織染色(IHC)に最適 IDO1 / NM_002164 UltraMAB® 抗体
背景
IDO1 / NM_002164
IDO1遺伝子は、トリプトファン異化作用からN- フォルミルキヌレニンへの第一段階かつ律速段階の反応を触媒するヘム酵素であるインドールアミン-2, 3- ジオキシゲナーゼ(IDO)をコードする。本酵素はD- トリプトファン、L- トリプトファン、 5- ヒドロキシトリプトファン、トリプタミン、セロトニンといった複数のトリプトファン基質に作用する。また、抗菌や抗がんを目的とする防御、神経病理学、免疫調節、抗酸化活性といった様々な病理生理学的プロセスにおいて役割を担うと考えられる。樹状細胞、単球、マクロファージにおける発現を介し、主要アミノ酸であるトリプトファンの周辺細胞分解により本酵素はT細胞行動を調節する{RefSeq Feb 2011}。
製品データ
![]() 図.1 パラフィン包埋したヒト肺組織の細胞腫をanti-IDO1 マウスモノクローナル抗体を使って免疫組織化学染色(UM500091) |
![]() 図.2 パラフィン包埋したヒト子宮内膜組織の腺がんをanti-IDO1 マウスモノクローナル抗体を使って免疫組織化学染色(UM500091) |
![]() 図.3 パラフィン包埋したヒトリンパ節組織をanti-IDO1 マウスモノクローナル抗体を使って免疫組織化学染色(UM500091) |
![]() 図.4 パラフィン包埋したヒト扁桃組織をanti-IDO1 マウスモノクローナル抗体を使って免疫組織化学染色(UM500091) |
詳細情報
| 遺伝子名 | Homo sapiens indoleamine 2,3-dioxygenase 1 (IDO1) | ||
|---|---|---|---|
| 別名 | IDO; IDO-1; INDO | ||
| 抗原 | Full length human recombinant protein of human IDO1(NP_002155) produced in HEK293T cell. | ||
| バッファー | PBS (PH 7.3) containing 1% BSA, 50% glycerol and 0.02% sodium azide. | ||
| クローン | UMAB126 | アイソタイプ | IgG1 |
| 交差種 | Human | 濃度 | 0.5~1.0 mg/ml (Lot Dependent) |
| 精製 | Purified from mouse ascites fluids by affinity chromatography (Protein A or G Sepharose) | ||
| 適用 | IHC, 10K-CHIP | 推奨 希釈条件 |
IHC 1:100~200, |
IDO1 / NM_002164 UltraMAB® 抗体
| 品名 | メーカー | 品番 | 包装 | 希望販売価格 |
|---|---|---|---|---|
Anti IDO1, Human (Mouse) , UMAB126![]() |
ORG | UM570091 | 30 UL [1.00mg/ml] |
¥75,000 |
Anti IDO1, Human (Mouse) , UMAB126![]() |
ORG | UM500091 | 100 UL [1.00mg/ml] |
¥204,000 |
商品は「研究用試薬」です。人や動物の医療用・臨床診断用・食品用としては使用しないように、十分ご注意ください。






















このページを印刷する